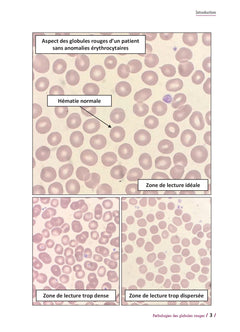
Pathologies des globules rouges

Contenu
Notre programme qualité
Dans notre entrepôt à Beauvais, un contrôle qualité est effectué minutieusement sur tous nos livres par nos équipes compétentes avant la mise en vente pour déterminer l’état et vérifier qu’il respecte notre charte de qualité. Certains produits peuvent présenter des signes d’usure minimes, les livres comme les accessoires (CD, cahiers d’exercices…) mais seulement si cela ne nuit pas à la lecture. Si vous rencontrez le moindre problème concernant l’état des livres reçus, cliquez ici, notre équipe en charge du service client est à votre disposition et fait son possible pour vous aider.Ce contrôle permet de déterminer une classification de nos livres détaillée ci-dessous.
Description de l’état d’un livre :
Très bon :
- Livre en excellent état, presque comme neuf, il a été lu très peu de fois
- Présence de quelques marques d’usure mais à peine perceptibles
- Les pages ne sont ni écornées, ni annotées, ni tachées
- La couverture est en parfait étatVous pouvez offrir ce livre à vos proches sans aucun doute !
Bon:
- Livre déjà lu et usagé
- Quelques légères marques d’usure (marque de crayon, page un peu écornée)
- Aucune page n’est manquante
- La couverture est intacte
Correct:
- Livre usagé avec des marques d’usure visibles (marques de crayon, pages écornées, petites annotations)
- Aucune page n’est manquante, marques d’usure sans nuire à la lecture (marques de crayon, pages écornées, petites annotations)
- Les accessoires sont présents mais peuvent avoir des marques d’usure
- La couverture de protection peut être manquante
Le Pitch
Le Pitch
Détails du livre
Auteur
Pathologies des globules rouges
Contenu
Notre programme qualité
Dans notre entrepôt à Beauvais, un contrôle qualité est effectué minutieusement sur tous nos livres par nos équipes compétentes avant la mise en vente pour déterminer l’état et vérifier qu’il respecte notre charte de qualité. Certains produits peuvent présenter des signes d’usure minimes, les livres comme les accessoires (CD, cahiers d’exercices…) mais seulement si cela ne nuit pas à la lecture. Si vous rencontrez le moindre problème concernant l’état des livres reçus, cliquez ici, notre équipe en charge du service client est à votre disposition et fait son possible pour vous aider.Ce contrôle permet de déterminer une classification de nos livres détaillée ci-dessous.
Description de l’état d’un livre :
Très bon :
- Livre en excellent état, presque comme neuf, il a été lu très peu de fois
- Présence de quelques marques d’usure mais à peine perceptibles
- Les pages ne sont ni écornées, ni annotées, ni tachées
- La couverture est en parfait étatVous pouvez offrir ce livre à vos proches sans aucun doute !
Bon:
- Livre déjà lu et usagé
- Quelques légères marques d’usure (marque de crayon, page un peu écornée)
- Aucune page n’est manquante
- La couverture est intacte
Correct:
- Livre usagé avec des marques d’usure visibles (marques de crayon, pages écornées, petites annotations)
- Aucune page n’est manquante, marques d’usure sans nuire à la lecture (marques de crayon, pages écornées, petites annotations)
- Les accessoires sont présents mais peuvent avoir des marques d’usure
- La couverture de protection peut être manquante